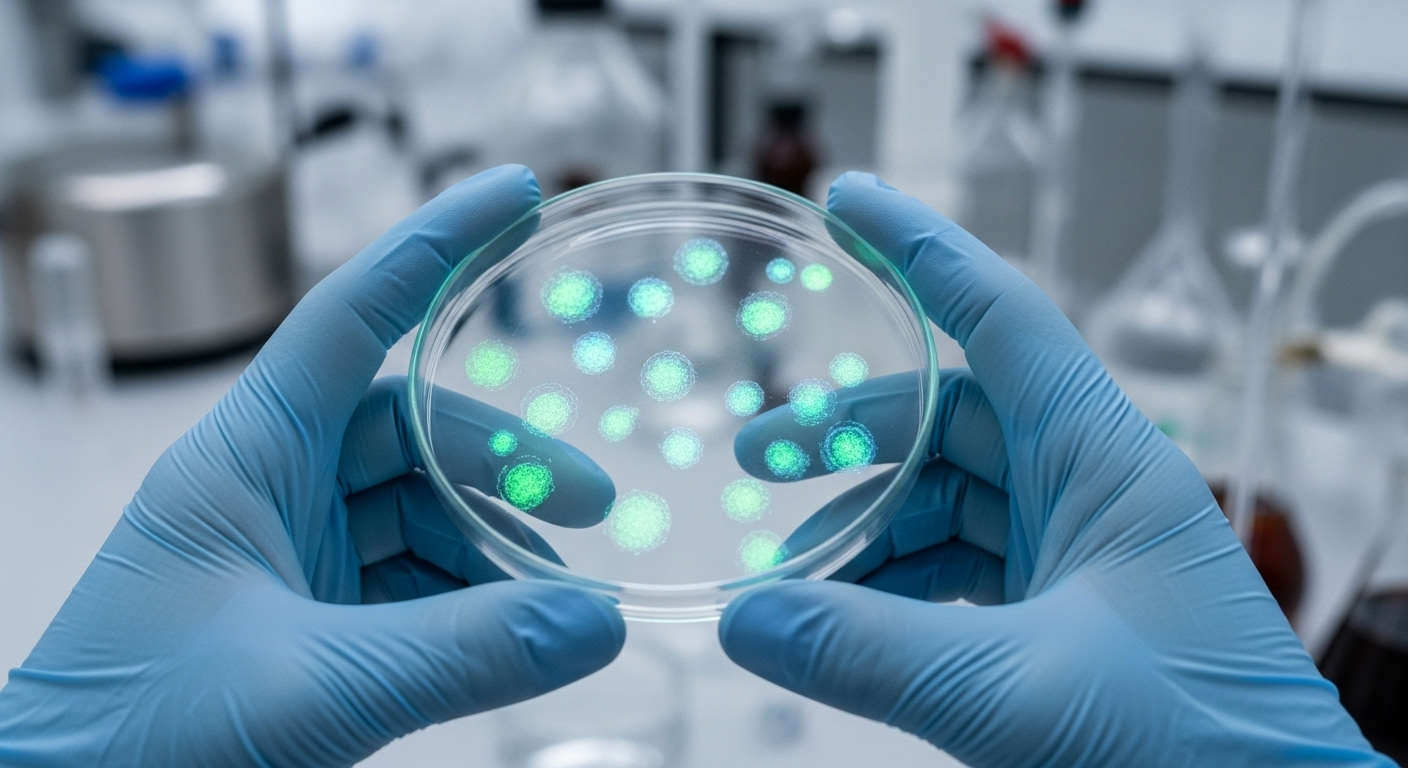
Ressusciter un gène, comment c'est possible ?

Un gène perdu par les ancêtres humains il y a des millions d’années pourrait ouvrir la voie à un traitement de la goutte
Auteur: Mathieu Gagnon
Imaginez une douleur si vive, si soudaine, qu’elle vous réveille en pleine nuit. C’est souvent comme ça que commence une crise de goutte. Une souffrance bien connue, mais dont les traitements actuels ne sont pas toujours parfaits. Et si la solution se cachait… dans notre propre passé ? Des chercheurs ont eu une idée un peu folle : réactiver un gène que nos ancêtres ont perdu il y a des millions d’années. Une idée qui pourrait tout changer.
La goutte, c'est quoi au juste ?

Pour faire simple, la goutte est une forme d’arthrite. Elle survient quand il y a trop d’acide urique dans le sang. Cet excès se transforme en petits cristaux pointus, un peu comme des éclats de verre, qui viennent se loger dans les articulations. Et là, ça fait très, très mal. C’est une inflammation soudaine et violente qui peut durer des jours.
Ce n’est pas une maladie rare, loin de là. On estime qu’environ 1 personne sur 25 dans le monde est touchée. C’est un vrai problème de santé publique.
Le chaînon manquant de notre ADN

Alors, pourquoi avons-nous ce problème ? La plupart des autres mammifères, eux, n’ont pas la goutte. La raison est simple : ils possèdent un gène actif pour une enzyme appelée uricase. Cette enzyme est une sorte de nettoyeur : elle décompose l’acide urique et l’empêche de s’accumuler. Mais nous, les humains et les autres primates, avons perdu la fonction de ce gène au fil de l’évolution.
Certains scientifiques pensent que cette perte a eu un avantage : des niveaux d’acide urique plus élevés auraient aidé nos ancêtres à transformer le sucre des fruits en graisse, ce qui était utile pour survivre aux hivers et, peut-être, développer de plus gros cerveaux. Un avantage d’hier qui est devenu un problème aujourd’hui.
Ressusciter un gène, comment c'est possible ?
L’idée des chercheurs n’était pas de remonter le temps, bien sûr. Ils ont utilisé des techniques modernes pour deviner à quoi ressemblait la séquence de ce gène ancestral. En comparant l’ADN de nombreuses espèces actuelles, ils ont pu le reconstituer virtuellement.
Ensuite, grâce à l’outil révolutionnaire CRISPR, souvent appelé « ciseaux génétiques », ils ont inséré ce gène « ressuscité » dans des cellules humaines en laboratoire. Pas n’importe lesquelles : des sphéroïdes de foie, des sortes de mini-organes en 3D qui imitent le fonctionnement d’un vrai foie. C’est un peu comme si on avait réinséré une page manquante dans le grand livre de recettes de notre corps.
Les premiers résultats sont très encourageants

Et ça a marché ! Dans ces cultures de cellules, l’insertion du gène ancien a fait son travail. Le taux d’acide urique a nettement baissé. Et ce n’est pas tout : l’accumulation de graisses liées au sucre des fruits a aussi diminué. C’est une double bonne nouvelle.
Comme le dit Eric Gaucher, l’un des auteurs de l’étude, « les cellules humaines savent encore quoi faire avec cette protéine ». C’est la preuve que la notice de montage n’est pas si perdue que ça. Notre corps a gardé la mémoire de cette vieille fonction.
Pourquoi cette approche pourrait être meilleure

Il existe déjà des traitements qui utilisent une enzyme uricase. Le problème, c’est qu’elle provient souvent d’animaux, comme le porc ou le babouin. Notre corps la voit comme un élément étranger et peut déclencher de fortes réactions immunitaires, parfois dangereuses.
L’avantage énorme de cette nouvelle thérapie génique, c’est que ce sont nos propres cellules qui produiraient l’enzyme. En théorie, le corps la reconnaîtrait comme sienne, ce qui réduirait massivement les risques d’allergies et de rejets. Le Dr Chen Xie, un rhumatologue qui n’a pas participé à l’étude, parle même d’une possible « thérapie curative sans médicament », ce qui changerait la vie de millions de patients qui peinent à suivre leur traitement au quotidien.
Calmons le jeu, ce n'est pas pour demain

Il faut rester prudent. Pour l’instant, tout cela n’a été testé que sur des cellules en laboratoire. C’est une étape cruciale, mais on est encore très loin de la pharmacie du coin. La prochaine étape pour les chercheurs est de passer aux tests sur des souris. Ils prévoient d’utiliser des systèmes de livraison par nanoparticules pour amener les outils CRISPR directement dans les cellules du foie.
Le chemin est encore long, semé d’embûches, et rien ne garantit le succès final chez l’humain. Mais la piste est incroyablement prometteuse.
Conclusion : le passé, notre futur médecin ?

Au-delà de la goutte, cette étude ouvre une porte fascinante. L’idée d’aller piocher dans notre propre histoire évolutive pour concevoir les médicaments de demain est… eh bien, c’est de la science-fiction qui devient réalité. C’est ce que l’on appelle la médecine évolutive.
L’objectif ultime, comme le résume le chercheur Eric Gaucher, est de « marier l’évolution moléculaire et la médecine clinique ». Qui sait quels autres secrets, quelles autres solutions oubliées se cachent dans notre vieil ADN ? Peut-être que les remèdes aux maux de demain sont inscrits en nous depuis la nuit des temps.
Selon la source : livescience.com










